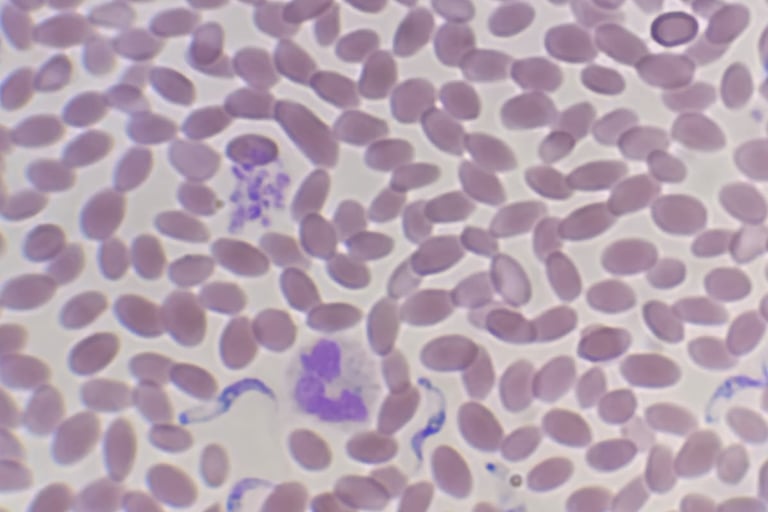
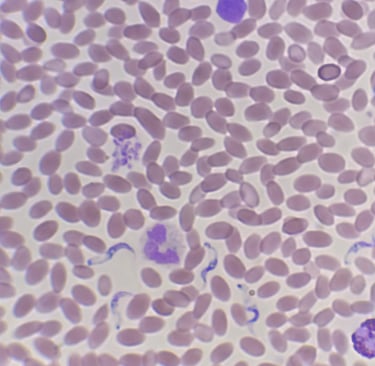

The highest standard of care is our service
Research and Development
Our research materials are proprietary property. please contact the relevant department for any assistance.

Camel breeding and Embryo Transfer
Disease Prevention
As an innovative leader in the field, we specialize in effective camel breeding programs. Our extensive work portfolio includes cutting edge projects in camel reproduction and embryo transfer technologies.
Integrated parasitic management (IPM), antimicrobial resistance and food security.
Frequently Asked Questions
What research do you conduct?
We focus on camel disease research to improve their health and welfare in Qatar and the Gulf region.
How is research applied?
Can I access your findings?
Who leads your research team?
What sectors does nawames cover?
Our research team shares findings with clinics and pharmaceutical partners to enhance veterinary services.
Our dedicated research and development sector works closely with veterinarians to study camel diseases and improve treatment methods regionally.
Research results help improve medicines, treatment practices, and animal welfare across veterinary service and pharmaceutical distribution.
Our skilled veterinarians and scientists collaborate on studies critical to camel health in the Gulf states.
